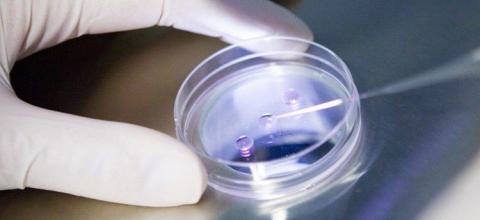

ΠΕΡΙΟΔΙΚΟ ΣΥΓΧΡΟΝΗ ΑΣΤΥΝΟΜΙΑ
Πρέπει να θεωρείται το επάγγελμα του αστυνομικού ως επικίνδυνο και ανθυγιεινό;
Πέμπτη, 3 Οκτωβρίου, 2019 Έτσι και στην Αστυνομία η πτώση ξεκίνησε
Αν ζούσαν ο Θαλής ο Μιλήσιος, ο Πυθαγόρας, ο Ευκλείδης, ο Αρχιμήδης, η Υπατία και οι λοιποί Αρχαίοι Έλληνες μαθηματικοί